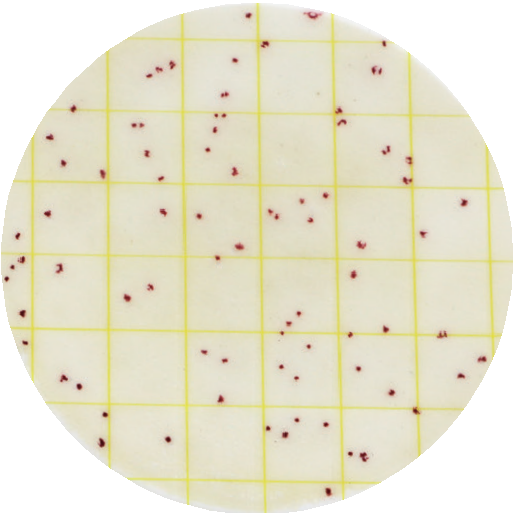
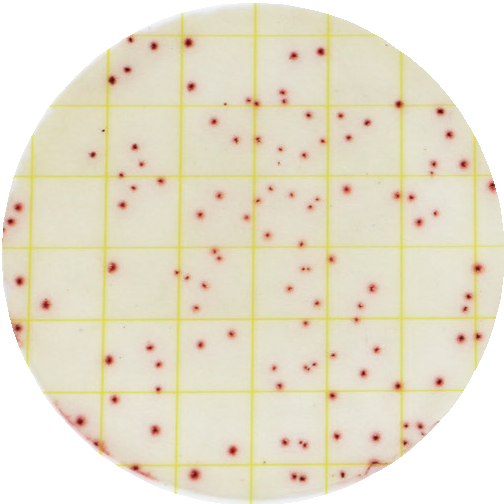

本品为完全即用型微生物检测培养基,以GB 4789.2标准指定的PCA平板计数琼脂为核心基底,无需配制,开箱即用,大幅提升检测效率。
营养体系科学配比:胰蛋白胨提供均衡碳源与氮源,满足微生物基础代谢需求;酵母浸粉富含B族维生素等生长因子,助力微生物快速增殖;葡萄糖为微生物生长提供高效能源,三者协同保障菌落稳定生长。
精准计数与便捷判读:培养基中特别添加TTC显色剂,菌落形成后可呈现清晰红色,有效区分杂菌与目标菌落,降低视觉判读误差。产品采用塑料硬板设计,无卷翘,零干扰,直径7cm培养层,接近传统9cm培养皿的观察视野,便于实验人员快速识别、精准计数。
扩散均匀,吸收迅速:依托独家特殊工艺,样液滴加后可快速扩散均匀,确保菌落分布分散无聚集;30秒内样液即可完全吸收,侧立转移零渗漏,操作过程安全便捷,适配实验室批量检测、现场快速筛查等多场景使用,为微生物菌落总数检测提供稳定、高效、精准的解决方案。
【产品简介】
菌落总数测试片为完全即用型培养基产品,其营养成分为胰蛋白脉、酵母浸粉、葡萄糖等,符合GB 4789.2标准对测试片的要求。为了更好的进行菌落计数和判读,培养基中添加了TTC显色剂。本产品采用直径为7cm的培养板,接近直径9cm的培养皿,方便菌落观察和计数。
【产品用途】 适用于食品、饲料、饮料、食品原材料及环境中菌落总数的测定。
【储存条件与保质期】
2℃-8℃密封储存,有效期为18个月。
使用前先将测试片恢复至室温后再加入样液。已打开包装未使用的测试片需要将测试片放回袋中,铝箱袋二次折叠后用胶布黏上或封口夹封口,2℃-8℃储存,并于一个月之内用完。未开封的测试片可在常温下运输及短期保存。
【操作步骤】
1.样品制备
称取样品25g(mL)置于盛有225ml稀释液(磷酸盐缓冲液或生理盐水)的无菌均质袋内,均质1min-2min,制成1:10的样品匀液。
特别注意:若样品过酸或过碱时,用1mol/L NaOH或1mol/L HCL溶液调节样品匀液pH至6.8-7.2之间。
2.样品稀释
用1mL无菌吸管或移液器吸取1:10匀液1mL,注入含有9mL稀释液的试管内,使用振荡器振摇后制成1:100的样品匀液,以此类推,制备10倍系列稀释的样品匀液,每次换一支吸管或移液枪头。
3.接种
根据对样品微生物污染状况的估计,选择2-3个稀释度样品匀液进行接种检测,液体样品包括原液。每个稀释度接种不少千两张测试片。测试片使用前,自然平衡至室温。将测试片放在水平试验台上,缓慢揭开上层膜,将1mL样品匀液垂直滴加在测试片中心区域。缓慢盖上上膜,尽量避免气泡的产生,样液会自动均匀扩散。
4.培养
将测试片正置于培养箱内,最多可堆叠至20片。置于36℃±1℃,培养48h±2h;水产品30℃±1℃,培养72h±3h。
5.结果计数
肉眼观察,必要时借助菌落辅助计数装置,计数所有红色菌落(不论大小和清晰度)。合适的计数范围在30CFU-300CFU。记录稀释倍数和相应的菌落数量。应注意的是,若整个培养区域呈淡红色或呈密密麻麻针点状,可能是菌浓度过高,需对样品进一步稀释以获得更准确的计数。如需分离菌落进行进一步分析,揭开上层膜用接种针将菌落挑出使用。
6.计数要点
(1)微小的红色菌落也应计入,当有明显菌落弥散时,一团弥散记为1CFU;
(2)当菌落数量过多计数困难时,可选择几个有代表性菌落的小方格,计算平均菌落数,再乘以38,即可得到整个测试片的估算菌落数;
(3)整片变色或者只有靠近圆周边缘的部分有颜色时,注意观察下一个稀释度的菌落数,若下一个稀释度有菌落且在最佳计数范围内,应计数该稀释度的菌落数,若无菌落,可能是样品或稀释液存在问题;
(4)36℃±1℃、30℃±1℃培养温度并非适用于全部样本类型,有特殊培养需要,建议用户多条件对比观察。
|

|
|
|
大肠埃希氏菌 ATCC25922
|
金黄色葡萄球菌 ATCC6538
|
枯草芽孢杆菌 ATCC6633
|
【操作图解及视频】
【废弃物处理】
测试片在使用后,需在121℃、30min高压蒸汽灭菌处理后严格违守生物危害废弃物的处置规定处理。
【注意事项】
(1)取放测试片时,不要触碰培养基检测区域;
(2)计数时,可使用记号笔或菌落计数器,菌数过多时,可通过方格估算菌数;
(3)测试片不应放置于日光、紫外或荧光灯下直射;
(4)不要使用污染的测试片;
(5)使用后的测试片严格按照废弃物处理进行。
【用户需知】
由于食品基质的复杂性,选择测试片检测方法时,务必考虑到取样方法、检测方案、样品制备、处理和实验室技术等外部因素,这些因素都可能会影响结果。部分食品样品本身也可能会影响测试结果。
在选择本品进行菌落总数测定前,您应先评估该产品及所选方法是否符合特定食品基质和目标微生物。建议选择足够的样品进行验证。测试片质检方法可参考《GB4789.28-2024 食品微生物学检验培养基和试剂的质量要求》附录F中平板计数琼脂(PCA)的质量控制标准。
如果您在使用时,发现或证明本品存在缺陷,请及时联系青岛海博生物销售代表或其经销商,进行产品换货或退款处理。
相关资料:
RTCSP001 菌落总数测试片说明书 点击查看